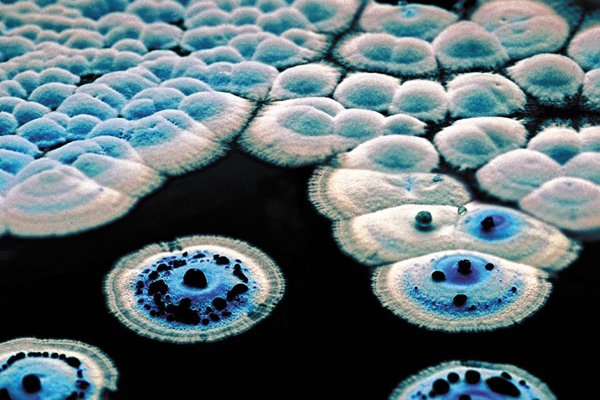
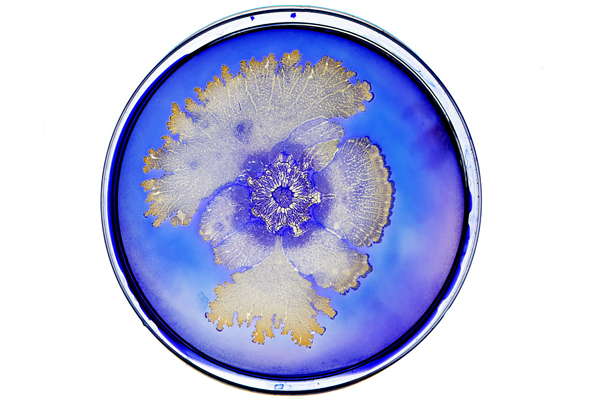

Bacterial World opening at Oxford University Museum of Natural History
19 October 2018

A new exhibition called Bacterial World that is opening at the Oxford University Museum of Natural History on 19 October is seeking to rehabilitate the reputation of bacteria and counter the popular misconception that they are all bad, or to be feared.
The exhibition incorporates 55 exhibits including art, geological and deep-sea specimens, film and digital interactive displays, featuring items loaned from institutions including the Wellcome Collection, the Pitt Rivers Museum and the Natural History Museum, London.
Aiming to demonstrate how science is lifting the lid on the secret lives and hidden stories of the smallest of organisms, Bacterial World will be featuring animals and plants which live symbiotically with bacteria and a display of ‘Top 10 Bacteria that Changed the World,’ as well as showing how bacteria might help tackle some of the world’s environmental problems.
President-elect of the UK Microbiology Society, Professor Judith Armitage FRS, is the lead scientist for the exhibition. She said; “I hope this exhibition goes some way to revealing the generally unknown and unseen vast, diverse world of bacteria. Bacteria have been evolving since the beginning of life on Earth and helped form the planet on which we live, providing the oxygen and much of the nitrogen needed for current life.
“Their complex communities, where they live and die, compete, communicate, cooperate, fight and have sex have evolved for specific environments and, we are coming to realise, are essential for healthy soils, oceans and even ourselves. While some, in the wrong place, can cause diseases, we need to understand microbial communities to be able to continue to control those diseases and to maintain both a healthy body and a healthy planet.”
The exhibition will be open from 19 October 2018 to 28 May 2019. For more information visit www.oum.ox.ac.uk/bacterialworld
Images from the Bacterial World exhibition
Image: Courtesy of Luke Jerram.